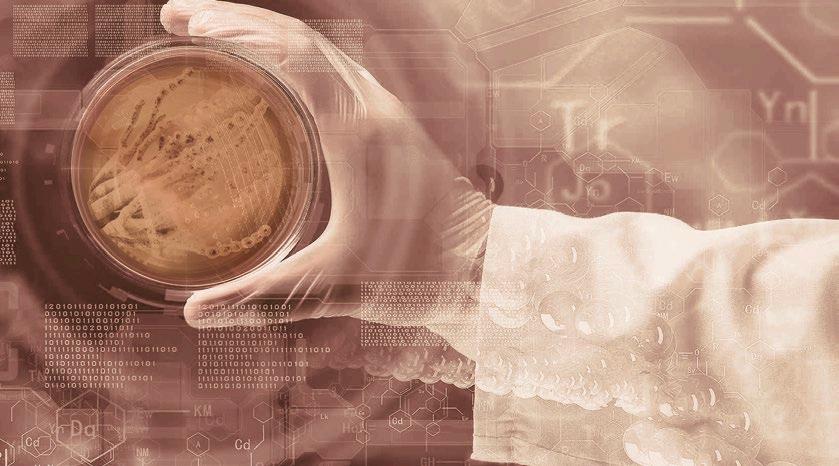
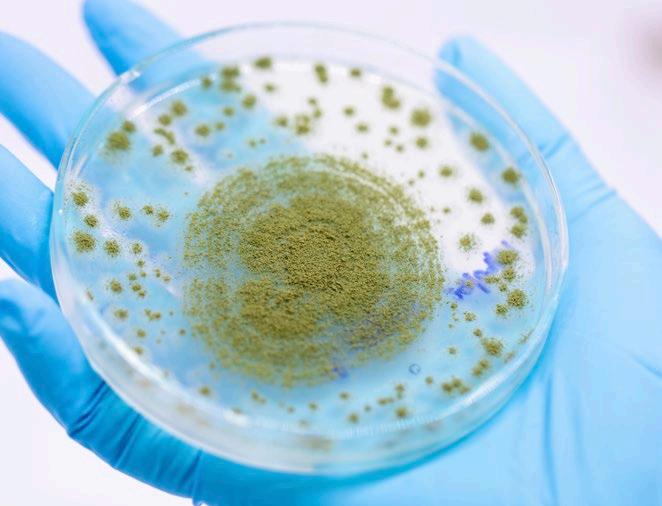

HARNESSING CLASSIC AND NOVEL INGREDIENTS AND TECHNOLOGY FOR ANIMAL NUTRITION
Animal nutrition is a dynamic field that constantly evolves to meet the ever-changing demands of the agricultural industry. As we strive to optimize animal health, performance, and sustainability, it is essential to strike a balance between traditional ingredients and cutting-edge innovations. In this edition, we explore the importance of classic ingredients, the significance of ingredient processing, and the promising potential of novel ingredients and technology in animal nutrition.
Conventional ingredients have traditionally formed the foundation of animal diets, providing essential nutrients for growth and development. These ingredients, including grains, forages, and oilseeds, offer a balanced combination of proteins, carbohydrates, fats, vitamins, and minerals. Their availability and affordability make them essential for meeting the nutritional requirements of animals across various production systems.
Moreover, the feed manufacturing processes employed to produce animal diets play a crucial role in optimizing nutrient availability and bioavailability. Techniques such as grinding, pelleting, and extrusion enhance digestibility, reduce anti-nutritional factors, and improve nutrient utilization, ensuring animals receive the maximum nutritional benefit from their feed. By investing in modern feed processing technologies, we can achieve greater efficiency in converting feed into animal products while minimizing waste and environmental impact.
Proper formulation of animal diets is paramount to ensure the provision of all essential nutrients required for optimal growth, reproduction, and overall health. Nutrient requirements vary depending on the animal species, age, physiological status, and production goals. An adequate balance of proteins, carbohydrates, fats, vitamins, and minerals is essential to support metabolic functions and maintain a healthy immune system.
Functional amino acids, such as lysine, methionine, and threonine, play vital roles in protein synthesis, muscle development, and overall animal performance. Their inclusion in animal diets, at appropriate levels, can optimize growth, feed efficiency, and immune function. Similarly, minerals like calcium, phosphorus, and trace elements are essential for bone development, enzyme function, and overall metabolic processes. Formulating diets with precise levels of these functional amino acids and minerals ensures that animals receive the necessary nutrients for optimal growth and productivity.
In recent years, the incorporation of novel feed additives has gained significant attention in animal nutrition research. Probiotics, beneficial bacteria or yeast cultures, promote gut health, improve nutrient utilization, and enhance the immune system. They help establish a healthy microbial balance in the gut, contributing to the overall well-being of animals. Similarly, phytobiotics, derived from plants, possess antimicrobial and antioxidant properties, supporting gut health and enhancing performance.
These innovative feed additives offer promising solutions to challenges such as reducing the use of antibiotics, improving feed conversion efficiency, and enhancing animal welfare. As alternatives to traditional growth promoters, they contribute to sustainable and responsible animal production while ensuring the safety and quality of animal products.
Achieving optimal animal nutrition requires a careful balance between traditional ingredients, ingredient processing, and innovative solutions. Classic ingredients provide a reliable foundation, while processing techniques enhance nutrient availability. Simultaneously, the exploration of novel ingredients and technology offers exciting opportunities to address sustainability concerns, improve nutritional profiles, and enhance animal health and welfare. Embracing both tradition and innovation allows us to develop sustainable, efficient, and welfare-oriented animal nutrition systems that meet the demands of a changing world. Continued research, collaboration, and investment in this field will enable us to unlock the full potential of classic and novel ingredients and technology for the benefit of animal production and global food security.
EDITOR
COMMUNICATION GROUP AGRINEWS LLC
ADVERTISING
Luis Carrasco +34 605 09 05 13 lc@agrinews.es
Anna Fernández Oller +34 609 14 50 18 af@agrinews.es
CUSTOMER SUPPORT Mercé Soler
EDITORIAL STAFF
Álvaro José Guzman
TECHNICAL DIRECTION
Dr. Edgar Oviedo (poultry) David Solà-Oriol (swine)
info@grupoagrinews.com nutrinews.com
grupoagrinews.com
Free distribution magazine
AIMED AT VETERINARIANS AND TECHNICIANS Legal Deposit Nutrinews B11597-2013
Subscription price 125$
Functional amino acids
Marcelo Dourado de Lima1 , Idael Matheus Góes Lopes1 ,Dalton de Oliveira
Fontes 2 and Soraia Viana Ferreira 3
1Post graduate student in animal science, Veterinary School of UFMG



2Full-time Professor, Department of Animal Science, School of Veterinary Science, UFMG
3DanBred - Swine Genetics, Patos de Minas
Idael Matheus Góes Lopes1 , Marcelo Dourado de Lima²
Bruno Alexander Nunes
Silva 3
1 PhD student in the Animal Science Graduate Program - Veterinary College at UFMG


2Masters student in the Animal Science Graduate Program - Veterinary College at UFMG
3Professor at the Institute of Agricultural Sciences at UFMG - Animal Bioclimatology, Nutrition

 Alba Cerisuelo IVIA
Lais Santana Celestino Mantovani PhD in Animal Science, professor at Centro Universitario UNIFATECIE
Alba Cerisuelo IVIA
Lais Santana Celestino Mantovani PhD in Animal Science, professor at Centro Universitario UNIFATECIE
Edgar O. Oviedo Rondón, Camila Alfaro-Wisaquillo, Gustavo Adolfo QuintanaOspina




Prestage Department of Poultry Science, North Carolina State University


 Braulio De La Calle Technical Director in ruminant formulation COREN agroindustrial.
Ayelén Chiarle Animal Nutrition Specialist
Braulio De La Calle Technical Director in ruminant formulation COREN agroindustrial.
Ayelén Chiarle Animal Nutrition Specialist
Fats and oils of vegetable origin as well as their by-products are considered raw materials that originate from various vegetable sources. These mainly include oilseeds such as soybeans, rapeseeds, sunflower or camelina. However, they may also derive from certain fruits like: olives, coconut or palm kernel.

 Alba Cerisuelo, IVIA
Alba Cerisuelo, IVIA
In addition to the original vegetable fats there is a group of industrial by-products derived from fats, including products such as:
oleins, residues from the refining of edible fats
lecithins, gums derived from the refining of industrial processes

glycerol or other by-products that can also be used as energy sources in animal feed
This type of fats tend to be found in liquid form(they possess a lower melting point than animal fats.) Nevertheless, there are specific instances where certain oils, like coconut or palm oil, defy the norm by having elevated melting points, resulting in a solid state when kept at room temperature.
Vegetable fats, like most fats, are mainly an energy source, provided in the form of lipids within feed.
Vegetable oils used in food businesses (category 13.1.19 of the catalogue of raw materials; UCO) are currently banned in animal feed.
With the exception of unheated oils, such as lecithin obtained during the production process, or vegetable oils utilized by food companies for cooking in compliance with Regulation (EC) No 852/2004, it is crucial that these oils have not come into contact with meat, animal fats, fish, or aquatic animals.

In contrast to animal fats, certain vegetable fats are either not produced in Europe or not sourced from crops grown in this region. Consequently, the utilization of these fats in animal feed can result in significant environmental impacts, as seen with soybean oil and palm kernel oil.
On the other hand, industrial by-products derived from these fats have lower environmental impacts due to their byproduct status, and may also have lower prizes.
Table 1 illustrates the classification of vegetable fats in the “Catalogue of raw materials” (Regulation (EU) 68/2013). These fats are categorized under section “2. Oilseeds, oilseeds and oil products thereof,” while industrial byproducts derived from fats, such as acid oils from chemical refining (oleins) or fatty acid distillates from physical refining, are classified under section “13. Other raw materials.”
2.20.1. Vegetable oil and fat1
13.6.1.
Acid oils derived from chemical refining2
13.6.5. Distillates of fatty acids from physical refining2
Table 1. Classification of vegetable fats and acid oils, obtained from the refining of fats according to the Catalogue of Raw Materials (Regulation (EU) 68/2013).
Oil and fat obtained from oilseeds or oily fruits(excluding castor oil obtained from the castor oil plant) through extrusion or extraction.


Product obtained during the deacidification of vegetable or animal oils and fats through the use of an alkaline agent. Followed by acidulation and the subsequent separation of the aqueous phase. It contains free fatty acids, oils or fats and natural components of seeds, fruits or tissues of animal origin such as monoglycerides, diglycerides, crude lecithin and fibers.
Product obtained during the deacidification of vegetable or animal oils and fats by distillation. It contains free fatty acids, oils or fats and natural components of seeds, fruits or tissues of animal origin. Including monoglycerides, diglycerides, sterols and tocopherols.
When the moisture content is > 1%.
Crude fat. When the moisture content is > 1%.
Crude fat. When the moisture content is > 1%
1The designation ‘vegetable oil and fat’ may be replaced by the term ‘vegetable oil’ or ‘vegetable fat’, as appropriate. In addition, the name shall be supplemented by the plant species and where appropriate, the specification of the corresponding part of the plant. It shall also be specified whether the oil or fat is crude or refined.
2An indication of botanical or animal origin, as appropriate, should be added to the name.
It is mandatory to declare the moisture content when it is greater than 1% and the crude fat content in the case of acid oils.
In general, fats of vegetable origin are obtained through mechanical pressing of the original raw material (seeds or oleaginous fruits). These oils can also be obtained through chemical processes that involve the use of solvents or through a combination of mechanical and chemical processes.

In such instances, although the oil extraction yield is higher, it is crucial to ensure the safety of the final product.
In regards to industrial by-products derived from vegetable fats, these are obtained through the refining of crude oils or fats.
The refining procedure involves eliminating free fatty acids and other unwanted components from oils, whether through chemical means (olein) or physical methods (distillate).


During the chemical refining process, triglycerides are separated from free fatty acids, which are responsible for the acidity. This is done through the addition of NaOH (neutralization step).
The free fatty acids are precipitated by the alkali, converting them into soaps that are separated from the rest through centrifugation.
These are acidified with sulfuric acid to obtain oleins (“acidulated soap stocks”; FEDIOL, 2020). Oleins are washed with plenty of water to drag the excess sulfuric acid, and they are then dried through decantation. This process gives rise to commercial oleins.
When using physical refining methods, free fatty acids are eliminated through distillation, where fats are exposed to high temperatures and vacuum conditions. (FEDIOL, 2020) This process leads to the production of fatty acid distillates.
In this context, both oleins and fatty acid distillates are characterized by their elevated free fatty acid content, surpassing 35%. This attribute gives them a significant energy value, often comparable to that of fat derived directly from its source.
Besides fatty acids, these raw materials might encompass additional compounds like essential fatty acids, tocopherols, polyphenols, sterols, and remnants of fat-soluble vitamins. These substances can be carried along during the processes of eliminating free fatty acids.

From a chemical standpoint both oils and crude fats are triglycerides (fatty acid esters and glycerin). Differing from one another according to the fatty acids that bind to glycerin.

The nutritional quality of these ingredients is directly linked to the length of the fatty acid chain or its saturation level (Wealleans et al., 2021). ingredients with shorter fatty acid chains and a higher degree of unsaturation possess a greater This holds particularly true for monogastric animals.
Long-chain polyunsaturated fatty acids (> 20 carbon atoms) have been found to be more detrimental to rumen microorganisms in ruminants compared to intermediate-chain fatty acids. Consequently, the presence of these long-chain fatty acids can potentially decrease the digestibility of other nutrients.
As discussed in a previous section regarding animal fats, the chemical quality and nutritional value of various sources of these fats are influenced by factors such as purity, unsaponifiable lipids content, presence of free fatty acids, peroxide levels, and the potential presence of toxic dioxins. These factors play a crucial role in determining the overall quality and stability of animal fats.
Globally, the MIU value is considered as a potential quality indicator that considers the moisture (M) of the sample, the level of impurities (I), and the quantity of unsaponifiable matter (U). This type of index is valuable for categorizing raw materials like industrial by-products derived from fats, as they often have higher impurity levels. Such a classification, as highlighted by studies conducted by Jiménez-Moya et al. (2021) and Varona et al. (2021), proves to be beneficial in assessing the quality of these materials.
FEDNA has published various tables for soybean, rapeseed, and palm oils, as well as soybean oleins and palm distillates. Additionally, INRAE-CIRAD-AFZ has also published their own tables. However, it’s important to note that conventional food tables like the ones provided by INRAE or CVB do not include the composition of industrial by-products derived from fats. In this context, the FEDNA tables stand out as a valuable resource for obtaining comprehensive information on the composition of these by-products.

In general, both oils and their byproducts are considered to have a composition of approximately 100% fat. Without the presence of: moisture, protein, amino acids or minerals (or with minimal contents of such nutrients).


Each source of oil or fat has a distinct composition of fatty acids. Soybean oil and oleins, for example, contain high levels of linoleic acid, while rapeseed oil is rich in oleic acid. Palm kernel fatty acid distillates, on the other hand, are characterized by a high concentration of palmitic acid. These variations in fatty acid profiles contribute to the unique characteristics and nutritional qualities of each oil or fat source.
In addition to their quality and composition, the nutritional value of vegetable fats depends on the species, sex and age of the animal in which they are used. These factors are capable of affecting the solubilization capacity and formation of micelles of these fats within the intestine. Influencing the digestibility of the different types of fat.
Broilers have a lower fat extraction capacity (Apparent Metabolizable Energy) from these raw materials compared to pigs.
Conversely, oleins and distillates are assigned a slightly lower energy value compared to their original crude oils. This difference can be attributed to their higher concentration of free fatty acids. However, recent research suggests that the bioavailability of oils in animal feed is influenced more by the degree of fat unsaturation rather than the content of free fatty acids (Jiménez-Moya et al., 2021).
Despite this fact, industrial by-products of vegetable fats continue to be a good source of energy in feed (Rodriguez-Sanchez et al., 2019). However, ensuring proper analytical control and standardization of these products is particularly important for accurate reassessment (Varona et al., 2021).

Palmitoléic,
1 https://feedtables.com/content/table-dry-matter; values expressed in dry matter.
2 http://www.fundacionfedna.org/ingrediente; values expressed in dry matter.

The inclusion of fat sources or oils in animal feed is primarily intended to enhance their energy density. This is because fats provide approximately 2.25 times more calories compared to carbohydrates and proteins. Moreover, fats contribute to improved feed conversion rates, palatability, and the overall granulation quality of animal feed.

The high energy content of fats has become highly coveted in animal feed production due to current productive demands. For example: high nutritional requirements of animals during certain physiological stages (hyperprolific sows, dairy cattle, etc.). As well as considering the need to formulate diets with criterions based on sustainability. This often involves substituting starch with fiber, which subsequently increases the demand for incorporating fats into the feed.
When including vegetable fat sources in animal feed, it is crucial to take into account that their degree of unsaturation is higher compared to animal fats.

Although it is true that unsaturation improves the digestibility of fats, it is also true that it reduces the stability of the products. This can lead to problems in the quality of the carcass if these types of fat are provided in high quantities at the end of the fattening stage.
On the contrary, saturated fats offer enhanced stability to the product, although they are perceived as less healthy. Nevertheless, it is recognized that the presence of unsaturated fatty acids in feed containing saturated fats can enhance their absorption.
Indeed, the proportion of saturated to unsaturated fatty acids in a fat source is widely acknowledged as one of the key factors influencing lipid digestibility (Powles et al., 1995). In this regard, a ratio of unsaturated to saturated fatty acids below 1.3 has been associated with a decrease in fat digestibility, as stated by Powles et al. (1995).
Khatun et al. (2017) demonstrated improvements in nutrient digestibility, animal growth, gut morphology, meat quality, and whey lipid profile with the use of a blend of polyunsaturated vs. saturated oils (4:2 ratio) in poultry feed.
As mentioned earlier, industrial by-products derived from fats generally have a lower energy level in monogastric animals compared to the original vegetable fat sources.
However, recent studies in broilers indicate that the partial substitution of crude palm kernel oil with soybean oleins (6% inclusion of soybean oleins; 2:4 ratio in the mixture) can improve fat absortion in animals during the fattening period (Jiménez-Moya et al., 2021).
This can be achieved without altering the AME content of the feed. Additional research also indicates that substituting soybean oil with soybean oleins does not alter the lipid profile of eggs, as suggested by studies conducted by Pardío et al. (2005) and Palomar et al. (2019).

On the contrary, as it happens in monogastric animals, unsaturated fats present greater digestibility at the intestinal level. Therefore, protected unsaturated vegetable fats (calcium soaps or hydrogenated saturated fats) are a tool for increasing daily intake and fat utilization in animals with high energy requirements, without affecting their metabolism.


Conversely, in ruminants, it is widely recognized that an excessive amount of fat, particularly unsaturated fatty acids, can adversely affect the growth of rumen bacteria, especially those involved in fiber digestion. This can consequently impact the digestibility of the ration.
Due to the high content of free fatty acids and the low pH of oleins, these can be potentially toxic to rumen microbiota when supplied in large amounts (Doreau and Chilliard, 1997). Additionally, they can enhance the acidogenic impact of concentrate feeds.
Nevertheless, certain studies suggest that the inclusion of sunflower oleins at low levels (3%) in lamb diets is feasible without adverse consequences (Blanco et al., 2013). It is worth noting that a considerable portion of the available calcium soaps are produced from palm distilled fatty acids (Handojo, 2017). Consequently, ruminants indirectly consume these ingredients in the form of protected fats.
Vegetable fats are an excellent source of energy and essential nutrients, due to their composition (high content of polyunsaturated FA) and their purity.
The commonly utilized vegetable fats in animal feed, such as soybean oil and palm kernel oil, are typically sourced from non-local origins, resulting in additional environmental consequences.
Conversely, the industrial by-products derived from these fats present environmental and economic benefits, serving as a promising energy source, particularly in poultry production. However, a thorough understanding of the fatty acid composition and quality of these by-products is essential for a comprehensive reassessment and accurate determination of their true value.
Vegetable fats, oils and their by-products (Raw Materials)
DOWNLOAD ON PDF


Optimal intestinal function relies on the gut microbiota, which plays a vital role in the metabolism and absorption of nutrients. It is also responsible for the proper assimilation of other compounds ingested by small animals. A well-functioning microbiota is characterized by a finely balanced and diverse array of microbial genera, providing the animal with enhanced metabolic capabilities within the intestinal environment.
The population dynamics of gut microbiota can be altered by factors such as:
Age;
Nutrition;
Stress;
Bacterial infectious diseases;
Hygiene;

Consumption of pre and probiotics.
(Pilla e Suchodolski, 2020)
The macronutrient composition of diets and the incorporation of certain targeted ingredients can effectively modulate the microbiota and its metabolites, thereby promoting the overall health of dogs.
Fiber emerges as a prominent compound among the various substances capable of modulating the microbiota, immune system, and intestinal integrity of dogs.



Dietary fiber includes polysaccharides and other substances associated with the cell wall of plants. These compounds are resistant to the action of mammal digestive enzymes due to the presence of β-type bonds (Van Soest, 1994).
While the animal’s own enzymes cannot digest these fibers, dogs harbor specific microorganisms that have the ability to ferment fiber. This fermentation process generates metabolites that contribute to favorable physiological changes, disease prevention, and provide alternative energy sources for cells in the intestinal mucosa. This phenomenon is particularly prominent in the colon.
It is worth noting that the fermentation of dietary fiber is more variable than the digestion of other macronutrients like: starch, fat and protein. This variation is mainly due to changes in the physicochemical properties of fiber.

Including:
Volume;
Viscosity;
Solubility;
Water retention capacity;
Degree of fermentability.
The use of fiber in dog diets has been questioned mainly due to the lack of knowledge regarding its nutritional function and by the fact that this species lacks the enzymes to digest such compounds.

However, new research has shed light on the importance of fiber and its role within dog nutrition. Associating its inclusion with positive effects in: intestinal transit regulation, maintaining intestinal integrity and function, as well as in the modulation of gut microbiota.
Studies have shown that these compounds are also capable of influencing: fecal consistency, dilution of food energy, appetite regulation and satiety in dogs, thanks to their physicochemical properties (Bosch et al., 2009; Sabchuk et al., 2017).
The extent of microbial fermentation of dietary fiber is influenced by its accessibility and the degree of access that gut microbial populations have to it. In monogastric animals like dogs, the large intestine serves as the primary site for the fermentation of these compounds. Fermentation of the soluble portion of fiber predominantly occurs in the proximal colon, whereas fermentation of the insoluble fraction continues throughout the distal colon.
In general, the fermentation of fiber is a highly complex process influenced by numerous factors within the gastrointestinal tract. These factors encompass the host, its microbiota, and the intricate interactions that take place between them.
As a general outcome, the fermentation of dietary fiber leads to the production of shortchain fatty acids (SCFAs, Figure 1) including acetate, propionate, and butyrate Additionally, the process generates gases such as hydrogen and carbon dioxide.

SCFAs are the main end products of the colonic bacterial fermentation of unabsorbed starch and non-starch polysaccharides. These in turn are the main organic anions present in colonic content (Bugaut, 1987).
On the other hand, branched-chain fatty acids (BCFAs), i.e., isobutyrate and isovalerate, result from the degradation of proteins by bacteria with pathogenic potential. Alongside short-chain fatty acids (SCFAs), the bacterial fermentation of fiber also results in the production of other metabolites, including lactate, ethanol, and succinate.
Short-chain fatty acids (SCFAs) are easily absorbed by the intestinal epithelium through passive diffusion and play a vital role in promoting bacterial growth. While SCFAs are primarily absorbed and metabolized by intestinal cells, they also serve as energy sources for other tissues, including the intestine, liver, and muscle.

Furthermore, the absorption of SCFAs stimulates the reabsorption of water and electrolytes, thereby playing a role in the osmoregulatory function of the intestine and affecting fecal moisture levels.

SCFAs present in the intestine stimulate the secretion of glucagon-like peptide 2 (GLP-2), an enteric hormone. GLP-2 promotes cell differentiation and proliferation, as well as the expression of specific genes involved in nutrient transport in the ileum. This ultimately enhances the digestive function of the intestine.
The improvement of mucosal growth also enhances its barrier function, leading to a reduction in permeability and the subsequent translocation of microorganisms (NRC, 2006)
It is important to note that the degree of fermentation and the profiles of SCFAs are influenced by the substrate, while the rate of fiber fermentation is determined by its composition, physicochemical properties, degree of lignification, particle size, and transit time in the digestive tract. These characteristics are directly influenced by the botanical origin of the fiber source, as well as its processing and particle size.

These microorganisms engage in the fermentation of endogenous and/or undigested nitrogenous compounds, including ammonia, biogenic amines, and branched-chain fatty acids (BCFAs). This process leads to the production of putrefactive substances, which are responsible for the unpleasant odor in feces, an undesirable effect for dog owners. Unfortunately, many of these putrefactive compounds have detrimental effects on intestinal health, such as increased permeability, dysbiosis, and enteritis.
Fiber has the ability to impact the composition and function of the gut microbiota by influencing the environmental conditions in which the intestinal microbial community develops (Brito et al., 2021). Furthermore, apart from serving as an energy source for colonocytes and promoting the growth and metabolism of beneficial bacteria, fiber also plays a role in lowering the pH of the intestinal lumen. This creates an inhospitable environment for the proliferation and establishment of potentially harmful bacteria, including Clostridium difficile and E. coli

Hence,in addition to providing a balanced diet with highly digestible proteins, the dietary inclusion of fiber can contribute to reducing the formation of putrefactive compounds in the colon of dogs.

Some genera such as Faecalibacterium spp., Blautia spp., Turicibacter spp., and Fusobacterium spp. are considered as “sentinel” bacteria. This is due to the fact that they are sensitive to changes in intestinal homeostasis and become significantly reduced in gastrointestinal diseases (Alshawaqfeh et al., 2017; Félix et al., 2022). Most of these genera are associated with fiber digestion and SCFA production.

Furthermore, the metabolites produced by these microorganisms have anti-inflammatory effects on the intestinal mucosa. It has been demonstrated that fiber intake also lowers the risk of various metabolic and inflammatory diseases:

Inflamatory bowel disease (IBD);
Cadiovascular disease;
Colorectal cancer (CCR);
Obesity;
Diabetes. (Honneffer et al., 2014; Pilla and Suchodolski, 2020).
Another interesting effect associated with fiber intake, is the potential modulation of gastrointestinal motility. Given that bacterial fermentation produces secondary bile salts and SCFAs, which can trigger contractions in the circular smooth muscle of the intestine (Eswaran et al., 2013).
In addition, increased dietary fiber intake can promote satiety. It has been found that diets with high fiber inclusion can increase satiety in dogs. This phenomenon is likely attributed to gastric distension, which leads to the release of cholecystokinin (CCK) (Weber et al., 2007). Consequently, gastric and intestinal distension stimulate the vagus nerve, triggering signals of satiety.

Studies have shown that incorporating significant amounts of fiber into the diet can enhance mucin production in the intestine. Mucin plays a crucial role in preserving immunity by preventing the translocation and attachment of pathogenic bacteria to the intestinal mucosa. Consequently, it indirectly influences the modulation of the intestinal microbiota (Saqui-Salces et al., 2017).
The presence of dietary fiber in the diets of dogs has a substantial impact on the intestinal microbial environment. It creates favorable conditions within the gut, promoting the growth of beneficial microorganisms and increasing the production of metabolites that contribute to healthy intestinal function. However, the effects of dietary fiber on intestinal function can vary depending on its specific physicochemical properties.
 Lais Santana Celestino Mantovani PhD in Animal Science, professor at Centro Universitario UNIFATECIE
Lais Santana Celestino Mantovani PhD in Animal Science, professor at Centro Universitario UNIFATECIE
Aquaculture is expanding significantly in Brazil and worldwide. According to a report from the Food and Agriculture Organization of the United Nations (FAO), the country will have a 104% increase in fish production by 2025.
Enhancing the performance of economically important species raised in intensive farming systems is a significant focus in aquaculture. Achieving productive success relies on various factors including genetics, management practices, proper speciesspecific nutrition, and cultivation methods. With the increasing demands of the expanding aquaculture industry, there is a need for research aimed at developing comprehensive, efficient, and economically feasible diets.
The inclusion of additives that enhance fish metabolism and improve health can be a valuable tool in promoting optimal animal development. These additives have the potential to positively impact growth, reproduction, and overall performance parameters, contributing to the overall well-being of the fish.


Aquaculture requires adequate water resources, where fish or other species of productive interest will remain throughout their cultivation period. Thus, disease proliferation or other distortions that may affect productive equilibrium can lead to negative impacts within the rearing environment. Resulting in important economic losses for the sector.

Antibiotic use in aquaculture has been a tool of choice for disease control and improving zootechnical performance in the past decades. However, antimicrobial abuse has led to the rise of multiresistant pathogens. Posing significant health risks both for animals and humans worldwide.
Residues from these compounds persist in fish tissues for extended periods, posing potential risks to consumers and disrupting the beneficial biota in aquatic environments.


Faced with these undesirable implications, there is a growing need to find alternative dietary supplements for fish. It is under such context that the use of probiotics, prebiotics and synbiotics represent a promising alternative. These products have the capacity to enhance the immune function of animals by nourishing and stimulating the growth of beneficial microorganisms. This beneficial microbial population, in turn, contributes to improved host metabolism by producing specific metabolites and inhibiting the proliferation of pathogenic microorganisms.
Upplementation options that include a combination of minerals and prebiotics in their composition offer valuable benefits. Microminerals, being essential for the formation of bones and tissues, as well as for the activation of enzymes involved in various biochemical processes (such as hormone synthesis), make them an important component of these products.
In fish, minerals can be absorbed directly from the water through their gills and integumentary system. However, in intensive production systems where fish need to achieve optimal performance within limited timeframes, nutrition becomes the most practical and efficient method for supplementing their mineral needs. Nutritional supplementation plays a crucial role in mitigating deficiencies of essential nutrients, ensuring the fish receive the necessary minerals for their growth and overall well-being.


Although the names of these additives are quite similar, they differ in terms of their function. Therefore, it is important to understand their effects and how they can influence productive results according to the product that is chosen.

Prebiotics are compounds that cannot be digested by enzymes. These include acids and salts produced in metabolic processes, and more specifically fermented by microorganisms of the gastrointestinal tract.
Hence, prebiotics play a role in preserving specific microorganisms that may be beneficial. They can also serve as adsorbents, attaching to mycotoxins present in the feed, preventing their absorption by the intestinal villi. These substances can be incorporated directly into diets or added as nutritional supplements.

Probiotics are living microorganisms that confer health benefits in host metabolism, when administered in quantities that are adjusted according to each species. They provide such benefits by enhancing a balanced microbiota, thus promoting improved nutrient digestibility. This leads to improved utilization of nutrients, strengthened immunity, and enhanced defense against pathogens and other health risks.
Synergistic combinations of these components, known as synbiotics, offer additional advantages. Synbiotics consist of a blend of prebiotics and probiotics, harnessing the benefits of both products. The synergistic effects between prebiotics and probiotics contribute to their efficacy. In aquaculture, synbiotics have been utilized with promising outcomes, promoting fish health and exerting positive effects on water quality.
The major impacts associated with the use of probiotics and prebiotics in aquaculture include:
Improvements in overall animal health: fish respond better towards handling as well as to the supply of feed. Exhibiting greater vigor and resilience.



Maintenance of beneficial microbiota: these compounds favor the survival and maintenance of beneficial bacteria within the gastrointestinal tract. Protecting intestinal villi from potential injuries and improving intestinal function.

Higher feed conversion efficiency and optimized nutrient absorption: the preservation of intestinal villi, and enhanced nutritional use, lead to improvements in zootechnical performance.
An established probiotic commonly used in aquaculture is Bacillus licheniformis. These probiotics are incorporated into complex formulations to enhance health and overall resistance in tilapia. They have been observed to increase the height of intestinal villi, thereby expanding the absorption area, as well as increasing the size and volume of liver cell nuclei. These changes serve as positive indicators of the fish’s nutritional status. Since the liver plays a crucial role in nutrient metabolism, the volume of hepatocytes can be indicative of the fish’s overall health. Therefore, any modifications, adaptations, injuries, or cell death in this vital organ hold significant importance.
In such scenarios, the incorporation of probiotic and prebiotic additives plays a pivotal role in enhancing animal health and well-being within demanding production systems. These systems often face various challenges such as low temperatures during specific seasons and exposure to pathogens.
It is important to emphasize that the microorganisms utilized as probiotics or prebiotics in aquaculture must adhere to strict sanitary standards to ensure the safety of all entities involved in the production chain. This includes the animals, the water, the producers, and the consumers. In addition to establishing a successful colonization within the digestive tract to provide benefits to the host, certain criteria must be met by these microorganisms. The following conditions are crucial:


They must be innocuous to water, humans and animals;
They must not possess antibiotic resistance genes and have antimutagenic and anticancer properties;
Resist feed manufacturing processes when they are inoculated;
Mannan oligosaccharides(MOS) are one of the most widely used prebiotic in animal diets. This compound is sourced from the cell wall of Saccharomyces cerevisiae, a yeast species. When combined with other components, it has the potential to enhance animal feed conversion rates and protein efficiency, ultimately optimizing nutrient utilization and overall performance.
They must also be resistant to the action of digestive enzymes, in order to reach their target tissue(intestinal epithelium) without losing their properties;

Possess sufficient durability to withstand standard storage times and transportation.

The utilization of probiotics, prebiotics, and synbiotics in aquaculture as dietary supplements is gaining momentum. Enhancing feed conversion rates, weight gain, and pathogen control are vital aspects of aquaculture. This makes these additives increasingly appealing for the industry. Additionally, it is important to recognize that their implementation contributes to the preservation of ecosystems in which this productive activity is carried out.
For such reasons, the use of probiotics and prebiotics in fish nutrition is highly recommended. Regarded as a valuable asset, these supplements can be integrated with other crucial elements such as effective management practices and genetic excellence. Moreover, their incorporation can aid in the preservation of essential antimicrobial compounds in the long run.

Use of prebiotics, probiotics & synbiotics as additives in aquaculture
DOWNLOAD ON PDF



Choline is an essential micronutrient for the growth and performance of swine and poultry.

Due to birds’ limited ability to synthesize sufficient choline, their diets require supplementation of this essential nutrient. Choline chloride 60%/75% (CC 60%/75%) is a commonly used synthetic feed additive in swine and poultry rations.

However, it is associated with various drawbacks that affect health and productivity, including reduced absorption rates, interactions with other nutrients, the production of trimethylamine (TMA) in the gastrointestinal (GIT) tract, leading to damage of intestinal villi and cell integrity due to its corrosive nature.
KOLIN PLUSTM produced by Natural Remedies based in India and serving to more than 35 countries across the globe.


In a choline deficient (CD) model created artificially, Cobb birds were randomized into four groups as follows:
Numerous Poultry, Swine, Shrimp & Ruminant experimental models have validated the effectiveness of KOLIN PLUSTM in improving animal performance.
The CD-induced model was created by substituting a portion of soybean meal in the broiler diet with soy protein isolate. The findings of the study demonstrated that KOLIN PLUSTM effectively reversed the adverse effects caused by the CD diet, similar to the CC 60% group, in broilers (Table 1)
For body weight $p<0.001 (significantly decreased) as compared to normal control, *p<0.05, **p<0.01, ***p<0.001 (significantly increased) as compared to CD. For FCR $p<0.001 (significantly increased) as compared to normal control and *p<0.05, **p<0.01, ***p<0.001 (significantly decreased) as compared to CD

Furthermore, a conventional model of naturally occurring choline deficiency was employed, where 308 Ross broilers were categorized into three groups:
Normal control (N), N + Choline chloride (CC) 60%, and N + KOLIN PLUS.
The birds in the Normal control group were provided with a diet lacking choline supplementation.
The research findings demonstrated that incorporating KOLIN PLUSTM in the diet of broiler birds with natural choline deficiency resulted in enhanced body weight and feed conversion ratio (FCR) comparable to the group supplemented with CC 60% (Table 2).
KOLIN PLUSTM demonstrates promising results in enhancing performance in both artificially induced and natural choline deficiency (CD) models, potentially attributed to its significant involvement in fat metabolism, mobilization, and optimal muscle growth.
Additionally, it exhibits comparable efficacy to the feed additive CC 60% even at a lower dosage (1/3) in both poultry and swine.
This makes KOLIN PLUSTM a low dose greener alternative which is free from TMA & Mycotoxins. Furthermore, its bioavailable, vitamin compatible, NonCorrosive, Non-Hygroscopic and safe for environment.

Therefore, KOLIN PLUSTM serves as a suitable alternative to synthetic CC 60% in swine and poultry diets.
For more details contact ganesh.s@naturalremedy.com or www.naturalremedy.com



Weaned piglets are often affected by enteric diseases that hinder the expression of their innate genetic potential. These diseases have detrimental effects on the integrity of the intestinal mucosa, leading to a reduced ability to efficiently absorb nutrients (Eriksen et al., 2019).
In most production systems, the prevention and treatment of gastrointestinal diseases in piglets, is mainly carried out through the use of antibiotics.



Besides their implementation for therapeutic purposes, some antibiotics are used as performance enhancers. This scenario can result in the surge of pathogenic bacteria that acquire resistance to commonly used antimicrobials. Posing serious health risks for both animals and humans worldwide. This significant health concern has led to bans on antibiotic use in several countries (AlbernazGonçalves et al., 2021).

Hence, various nutritional approaches have been formulated to substitute antibiotic growth promoters and alleviate the adverse consequences of enteric diseases on the growth of weaned piglets. Notably, the utilization of functional amino acids like tryptophan, threonine, and glutamate stands out. These amino acids play a significant role in enhancing intestinal health, resulting in improved overall productivity.

Functional amino acids help to modulate the intestinal mucosa’s immune function, stimulate enterocyte proliferation and improve the integrity of the intestinal barrier (Chalvon-Demersay et al., 2021).
The process of weaning commonly diminishes the immune response of piglets, compromising their efficiency and rendering them more vulnerable to viral and bacterial infections. In situations where immunological activity is compromised, the likelihood of disease occurrence notably rises. A clear example of this is the increased prevalence of gastrointestinal disorders, often characterized by diarrhea as a prominent clinical sign. These conditions have a substantial impact on animal performance.
This review aims to demonstrate the beneficial effects of functional amino acids like tryptophan, threonine and glutamine on the intestinal health of weaned piglets.

Intestinal disorders compromise intestinal integrity and permeability. Causing morphological and physiological alterations that promote villous atrophy and crypt hyperplasia. This hinders adequate nutrient digestion and absorption. Thereby reducing the efficiency of intestinal function (Xiong et al., 2019).
Following weaning, piglets experience a notable decrease in their feed intake as a result of the sudden shift from a liquid to a solid diet. This transition contributes to intestinal dysbiosis and various alterations in the intestinal environment, impeding the proper development and functioning of the intestine and its microbial population. As a consequence, the necessary conditions for optimal intestinal health and microbial activity are compromised.

Weaning-induced stress poses a considerable immune challenge for piglets, requiring a substantial supply of nutrients. These nutrients are utilized by immune cells that play a crucial role in the recovery of damaged tissues and the restoration of intestinal homeostasis, as outlined by (Li et al., 2018).
Weaned piglets are also subjected to physiological, structural and functional changes, which interfere with the activity of: endogenous enzymes, absorption processes, secretion processes and intestinal barrier function. The integrity of the intestinal barrier plays a vital role in preventing the invasion and translocation of pathogens. This is achieved by promoting the expression of transmembrane proteins, such as occludin and claudin, which form tight junctions and help maintain the integrity of the intestinal barrier.
Functional amino acids are termed as such due to their ability to influence the composition of the intestinal microbiome while providing nutritional advantages to the animal. They serve various purposes, including:
They contribute towards enhancing animal health levels.,growth and development.
They help modulate immune function, through the activation of T and B lymphocytes, which are responsible for recognizing and eliminating infectious agents such as viruses and bacteria;
They act in antibody production. Including imunoglobulins A (IgA), G (IgG) and M (IgM), which act against foreign agents within the body;
They promote the activation of pro-im ammatory substances, like interleukins IL-1, IL-2, IL-6, IL-12, interferon-gamma (IFN-γ) and tumor necrosis factor (TNF-α).
Intestinal permeability increases with barrier disruptions, allowing the penetration of pathogenic bacteria, antigens and toxins, which result in: inflammation, inefficient nutrient absorption, a higher incidence of diarrhea and a reduction in overall animal performance (Moeser et al., 2017)
The inclusion of specific functional amino acids, such as tryptophan, threonine, and glutamine, as a dietary approach to support animal well-being during critical periods like weaning, is a strongly recommended nutritional strategy (Le Floc’h et al., 2018).


Studies reveal that functional amino acids can provide extra energy inputs to the intestinal epithelium. Contributing towards intestinal development, regulating immunity, epithelial barrier function, as well as modulating the composition of intestinal microbiota by favoring its colonization with beneficial microorganisms (Kim e Duarte, 2021).
These functional amino acids are also involved in providing energy to enterocytes, which play a crucial role in nutrient absorption and maintaining intestinal barrier function. Therefore, their proper inclusion in the diet contributes to enhancing the utilization of dietary nutrients and promoting optimal growth and development in animals. (Chalvon-Demersay et al., 2021).
Pathogenic bacteria play a significant role in causing various intestinal disorders. The inclusion of tryptophan in the diet has shown an inhibitory effect on pathogenic bacterial populations. On the other hand, beneficial bacteria from the Bacteroidetes and Firmicutes phyla, known for their ability to produce short-chain fatty acids, contribute to regulating intestinal homeostasis. By promoting the growth of these beneficial bacteria, tryptophan supplementation can help maintain a balanced and healthy gut environment. (Liang et al., 2018).

When evaluating tryptophan supplementation at 0.2 and 0.4% in weaned piglet diets, researchers observed a reduction in the abundance of pathogenic bacteria such as Clostridium sensu stricto and Clostridium XI. As well as observing increased numbers of beneficial bacteria from the genera Prevotella, Roseburiae and Succinivibrio.
In a study conducted by Tossou et al. (2016), the impact of dietary supplementation with L-tryptophan was evaluated. The animals were subjected to three different levels of L-tryptophan supplementation (0.0%, 0.15%, and 0.75%). However, upon concluding the study, the researchers did not observe any significant effects on animal performance measures such as average daily gain, average daily intake, and feed conversion.

However, animals fed 0.75% L-tryptophan exhibited a significant response in parameters such as crypt depth (increase) and a reduction in villus/crypt ratio (V/C). The parameters mentioned above play a crucial role in determining the overall intestinal health of pigs.
The inclusion of L-threonine in the diet of weaned piglets had a positive impact on gut health and mucin synthesis. Piglets supplemented with L-threonine at a dosage of 2.0 g/kg of diet showed significant improvements in intestinal integrity and reduced inflammatory responses. These findings emphasize the beneficial effects of dietary L-threonine supplementation in promoting gut vitality and maintaining intestinal health in weaned piglets. (Zhang et al., 2019)

Threonine is also associated with adequate gastrointestinal function in piglets, as it improves mucosal and intestinal barrier stability.


Threonine is crucial in the synthesis of mucin, a glycoprotein that safeguards the intestine against excessive enzymatic activity and hydrochloric acid. Additionally, mucin acts as a physical barrier, preventing the entry of pathogens that can harm the intestinal mucosa. These effects highlight the essential role of threonine in maintaining structural homeostasis and intestinal morphology. (Zhang et al., 2019).
Mao et al. (2019) evaluated the effects of threonine supplementation on mucin production in weaned piglets. They assessed two supplementation levels: 0.74% and 0.89%, and found that animals supplemented with 0.89% presented an increase in mucin production. They suggested that this can improve intestinal barrier integrity.

Glutamine is associated with an effective proliferation of intestinal cells and lymphocytes, which corroborates its importance for the gastrointestinal tract and the immune system (Ma et al., 2021). It also promotes stability in intestinal morphology by preventing villous atrophy and ensuring adequate growth. Glutamines contributes to enhancing immune function, especially under inflammatory processes caused by enteric pathogens, such as Escherichia Coli (Ji et al., 2019).
In a study conducted by Luise et al. (2022), the effects of glutamine (Gln) supplementation in combination with glutamate (Glu) on the gut health of weaned piglets were investigated. The researchers concluded that the combination of these amino acids at ratios of 25:75 and 50:50 (Glu:Gln) had positive impacts on immune function and the integrity of the intestinal barrier. Notably, the 50:50 (Glu:Gln) ratio led to significant growth of goblet cells in the jejunum, contributing to the restoration of intestinal health in the piglets. These findings highlight the potential benefits of incorporating both glutamine and glutamate in the diet to support the gut health of weaned piglets.
The inclusion of functional amino acids, including tryptophan, threonine, and glutamine, in the diets of weaned piglets can help mitigate the negative effects of weaning. These amino acids have been shown to improve intestinal mucosa integrity, promote the colonization of beneficial microorganisms, and enhance the efficiency of the intestinal barrier. By incorporating functional amino acids, we can attain various beneficial effects that contribute to the overall health and well-being of weaned piglets.

Functional amino acids & intestinal health in weaned piglets
DOWNLOAD ON PDF
A reduced feed intake is usually observed when pigs are exposed to heat stress during a long period of time.



As they have a limited capacity to evacuate the heat, and due to the thermic effect of feeding, they modify their feeding behavior to limit their body heat production.
Main physiological and metabolic consequences of heat stress are impaired intestinal barrier function, perturbations to the hormonal system, changes in thermoregulation responses...
The sensitivity of insulin, a key hormone involved in the regulation of multiple metabolic processes such as the energy metabolism, may also be affected under heat stress.




LEVUCELL SB is the specific probiotic yeast Saccharomyces cerevisiae boulardii CNCM I-1079. More than 50 scientific publications in monogastric feeding have documented its beneficial effects on gut health.
Under heat stress conditions, LEVUCELL SB helps maintain optimal gut barrier integrity functions and reduces the risk of pathogen endotoxin translocation into the blood stream with associated inflammation.
Supplemented pigs with LEVUCELL SB better cope with heat stress. Lactation performance are improved, and fattening pigs are more efficient converting feed into growth.
Metabolic response adaptations
Insulin sensitivity
Thermoregulation response
Water intake Body temperature





Heat loss capacity increase
Pigs can better evacuate the heat

Adaptation of feeding behavior
LEVUCELL SB supplemented pigs eat more often with smaller meals for an increased daily feed intake
ENERGY








LACTATION AND GROWTH PERFORMANCE
Not all products are available in all markets nor associated claims allowed in all regions.
OVERALL BETTER ADAPTATION TO HEAT STRESS

EFFICIENCY LEVUCELL SB BENEFITS UNDER HEAT STRESS

1PhD student in the Animal Science Graduate Program - Veterinary College at UFMG
2Masters student in the Animal Science Graduate Program - Veterinary College at UFMG
3Professor at the Institute of Agricultural Sciences at UFMG - Animal Bioclimatology, Nutrition and Pig Production
Environmental challenges are a constant issue for highly productive sows reared in tropical climates. High productivity becomes a significant factor when it comes to the thermal comfort of lactating sows. Considering the fact that they must increase their feed intake during this phase in order to avoid losses in subsequent phases (Mendoza et al., 2020)

The thermal comfort zone of lactating sows ranges from 18 to 22 ºC with a relative humidity of 40 to 70% (Silva et al., 2021).

Factors such as radiation, air current, temperature and humidity, must be taken into account when adjusting the temperature range to the animal’s comfort zone. Which will optimize the expression of their genetic potential. Therefore, the adoption of adequate heat mitigation strategies as part of the management and housing practices used for highly productive sows, is nonnegotiable in countries with tropical climates.
Heat stress reduces feed intake, as it is a physiological adaptation of the body to reduce endogenous heat production associated with the caloric increments generated by food.
However, this may lead to negative consequences regarding the mobilization of body reserves, milk production, and longevity in sows.

As well as affecting reproductive performance, including fertility rates, and increasing weaning days at estrus (Williams et al., 2013)
At present, the implementation of nutritional strategies, including additives and modifications in diet formulation, plays a crucial role in stimulating feed intake among lactating sows. By alleviating the negative consequences of reduced consumption during lactation, these strategies have a positive impact on the productive and reproductive performance of sows. In the following discussion, we will explore several nutritional approaches that can effectively mitigate the effects of heat stress on lactating sows.



Pigs possess less efficient sweat glands compared to other animal species, resulting in heat dissipation primarily through respiratory rate and conduction, convection, and radiation. However, the effectiveness of these mechanisms can be influenced by various factors beyond ambient temperature. Additional factors such as air humidity, air velocity, and the surface area of contact with housing surfaces also play a role in modulating the efficiency of heat dissipation in pigs. (Bjerg et al., 2020; Brandt et al., 2022; Huang et al., 2022;).
The thermal environment in which sows find themselves can modulate their feeding behavior. Thus, temperature fluctuations directly influence their feeding behavior. With greater feed intake levels occurring under milder temperatures (Quiniou et al., 2000; Silva et al., 2009, 2018 e 2021). Dietary patterns are also influenced by environmental temperature and photoperiod variations (Silva et al., 2021)
Choi et al. (2019) conducted a study that revealed increased feed consumption in lactating sows experiencing heat stress when they were fed during the nighttime. These findings align with the results obtained by Silva et al. (2009 and 2021). In the latter study, researchers examined the performance of lactating sows across different seasons within the same year, with an average temperature of 26.2ºC compared to 23.1ºC and variations in thermal amplitudes ranging from 16.1 to 21.0ºC. The study reported higher feed intake, improved overall performance, and increased milk production in sows during the coldest season of the year.
High temperatures influence parameters that go beyond feed consumption. Several authors have reported variations in the reproductive performance of breeders, as well as increased mortality in piglets due to crushing. They also observed lower weight gains in piglets as a result of reductions in: milk production, amino acid content and fatty acid profiles (Silva et al., 2017; Silva et al., 2018; Oh et al., 2022)
Heat stress conditions have a detrimental impact on animal welfare, leading to various physiological responses as the animals strive to mitigate the adverse effects caused by the heat.
Liu et al. (2021) conducted a study on primiparous sows exposed to heat stress and found that heat stress prolonged the duration of calving. This increase in calving duration was associated with a higher number of stillbirths due to piglets experiencing hypoxia. Sows, in an effort to regulate their body temperature, increased their frequency of changing positions within the farrowing pen. Unfortunately, this intensified movement resulted in a higher incidence of piglet crushing, causing significant negative consequences.










Current sow genetic lines have higher lean tissue deposition rates and greater reproductive capacity, which increases their endogenous heat production (He et al., 2019). Therefore, researchers have looked into nutritional strategies such as: the inclusion of fibers (Oh et al., 2022), minerals (Chen et al., 2019) and additives (Rocha et al., 2022; Domingos et al.,2021; Silva et al., 2021) as potential alternatives to optimize efficiency in sows.

Rocha et al., (2022) evaluated the effects of dietary yeast supplementation (Saccharomyces Cerevisiae var. Boulardii), at different times in crossbred sows. This was done in sows under tropical and humid conditions, with temperatures ranging from 25.9 to 31.9 °C. They assessed the impacts that this type of supplementation had on: productive performance, as well as colustrum and milk production quality.
This is especially true, when talking about maintaining performance levels in sows that are raised in tropical environments.
Considering this aspect, Domingos et al. (2021) conducted a study to assess the effectiveness of incorporating yeasts as a feed additive. The objective was to enhance the nutritional utilization of diets, improve the health status, and increase milk production in sows. Similarly, Rocha et al. (2022) conducted studies with a comparable objective.
Supplementing sows with 0.04% and 0.08% during longer cycles, ranging from 90 days of gestation until weaning, resulted in increased daily milk production and daily weight gain. In sows during their 1st and 2nd cycles, from the 90th day of gestation to the 24th day of lactation, higher dry matter and protein content were observed specifically in their milk during the lactation period. Domingos et al. (2021) evaluated sow performance during late gestation and lactation under a tropical humid climate with yeast supplementation (Saccharomyces Cerevisiae var. Boulardii). The authors observed an increase in daily feed intake, total feed intake, and milk production in those animals supplemented with yeast, compared to those receiving other dietary treatments.

Ensuring the intake of necessary nutrients for maintenance and production is fundamental.
A study carried out by Mendoza et al., (2020), aimed to evaluate the dietary inclusion of Betaine This amino acid is a methyl and osmolyte donor,that contributes to reducing the animal’s energy requirements for maintaining adequate cellular hydration and ionic balance (Andrade et al., 2016).

Fiber inclusion in the diet is a common practice to stimulate feed intake. However, a greater inclusion of fiber, can also change the nutritional profile of diets. Its inclusion is associated with improved intestinal integrity and a change in colostrum profiles. This is attributed to the production of colostrum with higher fat content.
Nevertheless, Silva (2010) suggests that further investigation is required regarding the high incorporation of dietary fiber. This is because elevated fiber levels can potentially lead to an increase in visceral mass, subsequently resulting in higher metabolic heat production.
The authors included dietary betaine in feed during lactation as a strategy to mitigate heat in sows under heat stress conditions.
In contrast, no favorable outcomes were noted during the summer season. Nonetheless, supplementing with betaine during the lactation period in summer led to an increase in the size of subsequent milkings specifically in sows with four or more calvings.
In a study conducted by Oh et al., (2022), the inclusion of fiber in sow diets and its impact on heat stress were examined. The findings indicated that a 6.5% inclusion of total acid detergent fiber (ADF) during the gestation period was reflected in the subsequent lactation period. Improving feed intake, reproductive performance and milk production.

The inclusion of selenium (Se), which plays a role in redox metabolism, was the subject of a study carried out by Chen et al., (2019). They assessed the impacts of increasing the dietary supply of Se in sows subjected to heat stress without the use of cooling systems. The authors of this study reported improvements in: the pre-weaning survival of piglets, colostrum and milk composition, as well as in the antioxidant status of sows and the transfer of immunoglobulins to their offspring. These beneficial effects were observed regardless of the climatic conditions in which the trial was carried out.
Silva et al., (2021), set out to evaluate if improving the sensory properties of the diet and enhancing its palatability could increase the voluntary feed intake of sows under heat stress conditions. The authors previously observed that the average daily feed intake of sows was lower during the hot season, when compared to the cold season (5.56 vs. 6.80 kg/d).

A higher average daily feed intake was observed in animals that were fed a diet containing palatable feed, compared to those which were fed the control diet (6.42 vs. 5.36 kg/d). It was also seen that certain feeding patterns associated with the hot season became altered.
Enhancing the nutritional density of feed and making protein content adjustments have been identified as effective strategies in managing heat stress. Additionally, the type of diet provided plays a crucial role. A study conducted by Kim et al. (2015) demonstrated that sows fed liquid diets exhibited higher voluntary feed intake compared to those fed dry diets. Furthermore, the temperature of drinking water for sows is also significant. (Jeon et al., 2006) found that supplying cooler water temperature promotes increased voluntary feed intake.
Another factor that must be considered besides the previously mentioned nutritional aspects, is the floor temperature of maternity stalls. Taking into account that when such floors are cooled this leads to better animal welfare conditions. This contributes to reducing animals’ respiratory rate,as well as the temperature of their skin. It also enhances productive and reproductive performance in sows (Parois et al., 2018)
Silva et al. (2006) analyzed the effects of floor cooling on the productive and reproductive performance of sows kept under high temperature conditions during the summer. They observed that those sows which were kept on a cold floor exhibited a higher feed intake (6.47 vs. 5.61 kg/day). Leading to higher milk production and better milking performance, as well as exhibiting: a reduction in rectal temperature, surface temperature and respiratory rate. Similar results were observed by Silva et al. (2009) and Cabezón et al. (2017) when housing lactating sows in facilities with floor cooling.
Further research is required to determine the optimal nutritional strategies for mitigating heat stress in sows. The objective is to provide these animals with the optimal conditions that allow them to fully express their genetic potential without suffering any negative consequences.

It is crucial to consider environmental factors, such as facility control, when determining optimal housing conditions and management practices for sows. For instance, dividing diets into fractions and providing them during cooler periods and when sows have a higher natural inclination to eat can enhance voluntary feed intake. This optimization can lead to improved overall productivity.
Nutritional strategies to mitigate heat stress in lactating sows
DOWNLOAD ON PDF

 César Ocasio Vega, PhD. BioZyme Inc.
César Ocasio Vega, PhD. BioZyme Inc.
Recently, a novel category of feed additives has been introduced: postbiotics. The International Scientific Association for Probiotics and Prebiotics (ISAPP) defines postbiotics as a “preparation of inanimate microorganisms and/or their components that confer a health benefit on the host.”
All over the world, egg production is gaining popularity and importance, mainly fueled by increasing egg consumption. Therefore, there are some challenges that producers need to overcome to fulfill consumer demands.

The most urgent challenges are related to eggshell quality and hen lifespan.

Maintaining normal physiology and good health of the laying hen is essential to produce high-quality eggs for longer periods of time.
Dietary interventions like the feeding of fermented feeds, fiber, probiotics, prebiotics, and postbiotics are acceptable means for influencing the gut microbiota and its metabolic activity.
In laying hens, inclusion of postbiotics in the diet to maintain/improve productivity and egg quality has been researched and has led to the development and commercialization of a new feed additive, AO-Biotics® EQE (Egg Quality Enhancer).
AO-Biotics® EQE is a fungal postbiotic produced using patent pending technology and specifically indicated to improve the number of sellable eggs, egg mass, and productive lifespan of laying hens.


De Juan et. al. (2021) studied the effects of the dietary inclusion of 50 grams of EQE per metric ton of feed on the performance and egg quality traits of hens from 15 to 43 weeks of age. In this study, the addition of EQE significantly reduced the incidence of shell-less eggs.
In addition, from 15 to 21 weeks of age, the feeding of EQE increased egg production by 9% and improved feed conversion ratio (FCR) by 8%.

Motivated by these results, de Juan et. al. (2022) performed a second study extending the laying period of hens to 65 weeks of age.
In agreement with previous observations, the inclusion of EQE improved all major production traits at the peak of production, including increasing egg mass by 2%, egg production and egg weight by 1%, and FCR by 2%.
Several field trials have subsequently evaluated the inclusion of EQE in the diets of commercial laying hens. In agreement with findings reported by de Juan et. al. (2021 and 2022), the inclusion of EQE under commercial conditions improved egg mass, the number of sellable eggs per hen, and the productive lifespan of the flock.
In eight field trials involving more than 400 thousand laying hens, the supplementation of the AO-derived postbiotic resulted in approximately:
2% more egg mass,
reduction of 24% in the mortality of the flocks
2% more egg mass
3% more sellable eggs per hen
3% improvement in egg production
3% improvement in egg production, and
3% more sellable eggs per hen.
On average, a reduction of 24% in the mortality of the flocks was also observed, demonstrating that EQE improved the productive lifespan of the laying hens.
In recent years, there has been growing interest in postbiotics as a means of improving animal health and performance in the laying industry. The laying industry has traditionally relied on antibiotics to control bacterial infections and promote growth.
However, concerns over antibiotic resistance and residues in food products have led to a search for alternative solutions.

Postbiotics, such as AO-Biotics EQE, offer a promising alternative, as they have been shown to improve gut health and reduce the incidence of bacterial infections in laying hens.
Overall, field trial results were in line with findings found by de Juan et. al. (2021 and 2022) in controlled studies and support the proposition that EQE can contribute to improving eggshell quality, egg mass, and productive life span of laying hens.

The use of postbiotics in the laying industry represents an exciting development in animal nutrition, as it offers a natural and sustainable way to improve animal health and performance.

With its expertise in fermentation and natural feed additives, BioZyme Inc. is well positioned to continue developing innovative solutions for the laying industry and other sectors of animal agriculture.

The development of AO-Biotics EQE is a testament to the company’s commitment to improving animal health and welfare while also supporting sustainable food production — a commitment that began in 1951.
A developer and manufacturer of natural feed products for livestock and poultry production, BioZyme Inc. has emerged as a leader in the field of fermentation technology for animal feed.
With headquarters in St. Joseph, Missouri, the company has been at the forefront of developing innovative solutions for animal nutrition for more than 70 years.
An international team of expert microbiologists and nutritionists work together to develop natural feed products that optimize animal health and performance.

The company’s founder, Larry Ehlert, was a pioneer in the field of microbiology and fermentation, and his work laid the foundation for the development of AO-Biotics® Amaferm®, now one of BioZyme’s most notable products.

This breakthrough all-natural, proprietary feed additive was developed in the 1980s, and is a proprietary blend of natural enzymes and microbials that promote optimal digestion and livestock, including equine, dairy, beef, canine, sheep, goat, swine and poultry.
The product has been shown to improve feed intake, weight gain, milk production, and reproductive performance in animals, as well as to reduce the incidence of digestive disorders and other health problems.
BioZyme’s expertise in fermentation has been instrumental in developing innovative and effective animal nutrition products.
The company’s extensive research and development in fermentation technology have enabled it to develop products that help improve animal performance, health and well-being.

The company’s focus on using natural ingredients and processes in its products is especially important in today’s market where consumers are increasingly looking for more natural and sustainable alternatives.
BioZyme’s deep roots in fermentation and its continued commitment to research and development in this area make it well-positioned to continue developing new and innovative products to meet the ever-evolving needs of the animal nutrition industry.
The first-and-only AO postbiotic developed specifically for layers, using patent pending technology.
Get more sellable eggs, egg mass and productive life span with AO-Biotics EQE. Built on BioZyme’s 70 years of Aspergillus oryzae (AO) fermentation expertise to offer products that enhance animal health, welfare and productivity.

We are AO experts. We are Anything but Ordinary.
Care that comes full circle.
BioZymeInc.com
Introduction

Dietary amino acids (AA) and crude protein (CP) levels have been demonstrated to affect growth, body weight, body composition, organ development, and feathering in broiler breeder pullets. Breeder pullets are fed to achieve target body weights set up according to genetic line guidelines or specific company objectives. Meeting those growth objectives during the rearing phase has been related to optimum reproductive performance evaluated as egg production, fertility, and hatchability.

Specific feed allocations and feeding programs to obtain those target body weights every week could trigger an excess of AA and CP intake when the concentration of these nutrients is more than adequate.
This extra intake of AAs can lead to more significant breast muscle, reducing abdominal fat deposition. In contrast, low-CP diets have resulted in more abdominal fat deposition.
Abdominal fat is a desirable trait before light stimulation. Still, it is known that hens use breast proteins during the transition from pullet to sexual maturity and also during peak production as energy sources and for egg production.
Therefore, an adequate amount of breast or fleshing is also necessary to reach egg production standards.

A balance of breast development and fat reserves is advisable before light stimulation and the onset of production.


Studies during rearing commonly focused on extreme CP levels and the effects of AA have been evaluated in the laying phase. Very few studies have evaluated levels of AA during rearing close to the ones recommended by genetic lines.
We conducted a study aiming to determine the effects of four dietary AA levels on body weight and the development of breast muscle, organs, legs, and feathering on Cobb 500 slow-feathering (SF) broiler breeder pullets during the rearing phase from five weeks to the onset of egg production.
We also evaluated the effects on egg quality and production, fertility, hatchability, and embryo mortality from 24 to 65 weeks of age on these hens.
A total of 1,360 Cobb-500 slowfeathering (SF) pullets were randomly placed in 16-floor pens with 85 females per pen. Diets with corn, soybean-meal, and wheat-midds were formulated without CP restriction maintaining minimum ratios between essential AA and Lys on a digestible (dig) ideal basis.
Treatments consisted of four dietary AA levels with 80% (low-AA), 90% (moderate-AA), 100% (standardAA), and 110% (high-AA) of the Cobb-Vantress recommendations, guided by dig Lys using balanced protein (Table 1).

Up to 4 weeks, all pullets were fed a common starter crumble diet. Grower and developer mash diets were fed to pullets from 5 to 15 weeks and 16 to 24 weeks, respectively. Diets contained 2,700 kcal/kg of AMEn and 2,800 kcal/ kg of AMEn for the grower and developer phases.
The feeding program from 1 to 2 weeks was ad libitum, and after three weeks, it was restricted (Figure 1). In the developer phase, feed amounts varied slightly (±3 g/bird/ day) among treatments to maintain the body weight target close (±2%) regarding Cobb-Vantress (2018) guidelines.
Figure 1. Feed allocation (g/bird/ day) from 1 to 24 weeks of age of Cobb 500 SF broiler breeder pullets fed four different dietary amino acid levels during rearing low-AA, moderate-AA, standard-AA, high-AA corresponding to 80, 90, 100, and 110% of the CobbVantress (2018) recommendations, guided by dig Lys using balanced protein. n = 4 replicate pens per treatment of 85 pullets each.

At 22 weeks, 1,040 females and 112 males were transferred into 16-floor pens in a laying house with slats (17.35 m2 total area/pen) in a curtain-sided breeder house with a distribution of 65 hens and seven roosters per pen to keep a female: male ratio of 9.28:1
After 25 weeks, all hens were fed with one standard layer diet in two phases:
layer 1, from the first egg to 40 weeks,
layer 2, from 41 to 65 weeks with a similar amount of feed offered.
Feed increments were made according to egg production by treatment, and feed offered was decreased after the peak of egg production between 0.5 and 1g. In the whole experiment, all males were not subjected to treatments.


Cockerels were fed the standard treatment grower and developer diets during rearing and male diets during the laying phase, following Cobb-Vantress (2018) recommendations.
Pullets fed standard-AA and high-AA diets were heavier (P < 0.001) than those fed low-AA diets at 10, 15, and 20 weeks of age. High-AA diets resulted in better (P = 0.040) flock uniformity at 10 wk. Pullets fed a high-AA diet had the highest (P = 0.041) relative breast weight at 20 weeks of age and the lowest (P = 0.044) deposits of abdominal fat at 15 weeks of age.
Fleshing (Figure 2) increased (P < 0.05) as AA content rose in the diet, while the relative shank length (P < 0.001) and the number of wing juvenile feathers (P = 0.004) decreased.
Pullets fed the lowest dietary AA level had the longest (P = 0.007) small intestine relative to BW at ten weeks of age but a smaller (P = 0.001) liver than those fed moderate and standard-AA diets at 20 weeks.
Dietary AA levels affect pullet body weight, fleshing, and organ development during rearing with potential reproductive performance impacts.
Figure 2. Effect of dietary AA levels on fleshing score distribution in the flock of Cobb 500 SF breeder females at 20 weeks. n = 4 replicate pens per treatment of 3 pullets each.
During the laying phase, the body weight increased linearly (P<0.01) as AA augmented at 25, 36, and 40 wk.
Moderate-AA and standard-AA resulted in the best weekly egg production (Figure 3) and hen-housed egg production (HHEP) at 65 weeks, with 174.3 and 176.5 eggs, respectively.
Figure 3. Hen-weekly egg production (%) from 24 to 65 weeks of age for Cobb 500 SF broiler breeders fed four different dietary amino acid levels during rearing low-AA, moderate-AA, standard-AA, high-AA corresponding to 80, 90, 100, and 110% of the Cobb-Vantress (2018) recommendations, guided by dig Lys using balanced protein. n = 4 pens per treatment of 65 hens each.
Going one step beyond in animal nutrition means ceaseless research and development. Going one step beyond means anticipating developments in the livestock industry and offering the highest quality products and services. Going one step beyond means total commitment to overcoming all our customers’ challenges.

The optimum level of AA for HHEP at 65 weeks was estimated (P<0.001) in 96.7% and 94.7% by the quadratic and broken line models (Figure 4), respectively.

Figure 4. Effects of dietary amino acid levels during rearing as a proportion of the Cobb-Vantress (2018) recommendations on the average hen-housed egg production (HHEP) at 65 weeks of Cobb 500 SF broiler breeders determined by the quadratic broken line and quadratic (P = 0.002) models. (Z1 = (AA% < R) * (R – AA%) where (R – AA%) is defined as zero if (AA% > R); Z2 = (AA% > R) * (AA% - R).
y = -627.9432 + 16.670443* AA% - 0.0862344* AA%2 P = 0.002; R2 0 0.65; RMSE = 7.52
y = 183.919 - 2.085 * Z1 - 1.400 * Z2; RMSE = 7.85
Regression analysis
Quadratic Quadratic Broken line
Overall, the lightest egg weight (Figure 5) was obtained with 89%AA during rearing (P=0.022), and the heaviest eggs (P<0.001) were found at 54 weeks.

Figure 5. Egg weight (g) from 26 to 63 weeks of age for Cobb 500 SF broiler breeders fed four different dietary amino acid levels during rearing low-AA, moderate-AA, standard-AA, high-AA corresponding to 80, 90, 100, and 110% of the Cobb-Vantress (2018) recommendations, guided by dig Lys using balanced protein. n = 4 pens with 30 eggs per breeder at each evaluation time. * Significant differences in treatments per week. a-c Dietary treatments not sharing a lowercase letter in columns differ significantly by Tukey’s HSD test at (P < 0.05).
Response surface regression indicated linear effects on albumen and yolk percentages (P<0.01) increasing and decreasing, respectively, as AA levels augmented; consequently, AA had a negative linear effect on Y: A ratio (P=0.004) with quadratic effects (P<0.01) of age (R2=0.92) Fertility was not affected (P>0.05) by treatments, but AA had a quadratic effect (P=0.046) on hatchability up to 50 weeks of age, with 97% as optimum and decreased linearly (P=0.004) from 51 to 65 weeks.
A few effects of treatments (P<0.05) on embryo mortality were observed.
In conclusion, AA levels during rearing affect broiler breeder reproductive performance.
More details in:
Alfaro-Wisaquillo et al., 2021. Effects of amino acid levels during rearing on Cobb 500 slowfeathering broiler breeders: 1. Growth and development. Poultry Science 100 (9) 101327. doi.org/10.1016/j.psj.2021.101327
Oviedo-Rondon et al., 2021. Effects of amino acid levels during rearing on Cobb 500 slowfeathering broiler breeders: 2. Reproductive performance. Poultry Science 100 (10) 101398. doi.org/10.1016/j.psj.2021.101398
In the pursuit of efficient and sustainable production systems, it is essential to adapt feeding programs to each phase of the production cycle. This requires considering and working with degradation values and rates to optimize nutrient utilization.

Thermal treatments, and their application in raw materials and feed concentrates optimizes their utilization. Enhancing animal nutrition and overall performance.
The utilization of thermal treatments presents an opportunity to incorporate locally available raw materials that may not have been used otherwise. This enables the combination of these ingredients with other commonly used raw materials, thereby promoting the principles of a circular economy.
 Braulio De La Calle Technical Director in ruminant formulation COREN agroindustrial.
Braulio De La Calle Technical Director in ruminant formulation COREN agroindustrial.
Thermal treatments can be categorized into two main groups:
Dry treatments: involving the application of heat, drying, and roasting.
Wet treatments: involving the combination of heat and moisture, such as conditioning, cooking, granulation, expansion, and extrusion.
Wet or humid thermal treatments can be conducted using five distinct processes. Table 1 presents the operating conditions for these processes.
Conditioning: Application of thermal treatments without producing changes to the physical format of the ingredient. This process involves heating the feed, which, is usually done through indirect heat. Its main objective is to sanitize, (reduce or eliminate microorganisms), while facilitating a subsequent granulation process.
Granulation: It is the most common process used in feed mills nowadays. The trend in recent years has been to shift towards a higher percentage of granulated and crumb feed in different sizes. In this process, feed found in meal form, is transformed into granules (pellets) with different diameter and length. Achieving a final product with two fundamental properties: hardness and durability.

Expansion: This process uses temperatures ranging from 90°C and 120°C with lower pressure values than extrusion. It is also used to treat, and expand individual or combined products such as: corn, soybeans, wheat, cakes, etc.


Cooking and roller milling: Flakes are obtained through steam cooking at an approximate temperature of 100 °C for periods between 40 and 60 minutes. These are then subjected to the action of roller mills, where the drying takes place.
Extrusion is a highly intricate process that involves the manipulation of various variables. It utilizes an extruder, typically consisting of one or two sections, to carry out the treatment. Prior to entering the extruder, the raw materials undergo conditioning with the addition of liquids and steam. Inside the extruder, the materials are subjected to high pressure and temperature, typically ranging from 120°C to 170°C. The treated material is then expelled through a matrix, applying the highest pressure in the process.

Working conditions can be modulated according to variables and the combinations between them (Figure 1 ). They will basically depend on: the type of raw material or feed, the pre established objectives, and the type of animal for which that feed is intended These can also include the industrial capacities of each operator.

Physical modification of feed: Transform feed into meal and pellets of various formats. It facilitates intake, making feed more attractive, and in turn generating less waste.

Modify nutrients from a bromatological and chemical standpoint:
Allow adequate pellet formation, which confers them stability and improves their digestibility. Seeking three main objectives:
Gelatinization of starch.
Plasticization of particles: Fundamental to establish strong bonds between the particles.
Cell wall permeability: Facilitates the penetration and action of digestive juices.
Reduce/eliminate microorganisms:
Specifications regarding acceptable limits for microorganism levels in feedstuffs.
Salmonella: Absence in 25 g

E. Coli: Absence in 1 g
Fungi: Less than 104 cfu/g
Clostridium: Less than 100 cfu/g
Enterobacteriaceae in Pelleted Feed/ Sanitized Feed: Less than 100 cfu/g
Enterobacteriaceae in Meal Feed: Less than 105 cfu/g
The following section describes the structural modifications that nutrients undergo based on the specific treatment they undergo. These changes can be compared in Table 2

In general, the digestibility of starch tends to improve as the heat treatment variables approach the recommended limits and become more intense.


Protein improves to a certain extent , and then stabilizes when subjected to heat. The risk of denaturation increases significantly if the heat treatment is prolonged.
During the initial stages of these treatments, vitamins, enzymes, and other supplements may be lost. The extent of these losses tends to increase as the applied variables become more intense. The degree of damage and loss depends on the level of protection provided to these compounds and their inherent sensitivity.
As a general rule: A more intense use of variables, results in a greater reduction of microorganisms.
Typically, a duration of 40 seconds is adequate for effectively eliminating the most significant health-threatening microorganisms, particularly salmonella. However, it is important to emphasize that this holds true under the condition that the temperature remains above 80ºC and the steam humidity is maintained at a minimum of 3%.
It is a mechanical process that converts a mixture of ground raw materials into grains. This process is usually carried out in a granulator with the previous inclusion of steam, followed by a subsequent cooling phase where temperature and humidity are dissipated. Obtaining cylindrical particles with a higher density.
Some of the processes that take place before granulation, are:
Raw material grinding (pre-milling or grinding factory).
Mixing of raw materials to achieve a homogeneous mixture.
Conditioning (kneading with moisture and heat to produce a plastic and lubricated mass).

Previous compression through a matrix which allows to obtain a certain size and shape of pellet.
Screening to remove fine particles.
The final phase includes air drying and cooling.
To ensure proper conditioning of the feed, it is essential to achieve fluidization within the conditioner and thorough mixing with steam. This requires the shovels or paddles to evenly move the feed throughout the appropriately sized conditioners.

Advantages of granulation:
Improves animals’ productive yield.
Higher microbiological hygiene in relation to meal feeds.
Reduction of transport costs.
Improved digestibility, through starch gelatinization.
Elimination of anti-nutritional factors found in some vegetable raw materials.
It allows the use of more solid raw materials. As well as facilitating the combination of other raw materials and liquid additives.
It allows the use of less palatable raw materials.
The criteria used to assess pellet quality include:


DURABILITY:
It is a parameter used for the physical analysis of the feed. It evaluates the amount of fine particles which still preserve their cover after having been subjected to mechanical or pneumatic agitation. This assessment aims to simulate the transport and handling conditions of pellets under normal circumstances within the feed mill. This parameter is expressed as a percentage.
The level of fat will mark the durability. Hence, pellets intended for beef cattle consumption, may use a reference value of 97% or higher.

HARDNESS:
It is defined as the amount of force it takes to break a pellet or a group of pellets at the same time. This parameter is expressed in Kg/cm2
Water activity is a measurement of the unbound moisture content remaining in the pellet following the cooling phase. This unbound water is not associated with nutrients or other compounds in the feed. High levels of free water can create favorable conditions for the growth of fungi, bacteria, oxidative processes, and insect infestations. Water activity is quantified on a scale ranging from 0 to 1 aw (water activity).
An optimal reference value for feed is considered to be close to 0.65 a w and should never exceed the 0.7 a w mark.
It depends on where the sample is taken, but the reference value for robot obtained feed should be less than 3%.

Starch is the best and cheapest binder, since it provides binding strength, and elasticity. Which contribute towards improved durability. Gelatinization is normally achieved at 60ºC (Table 3 ) with 3% free water.

Wheat is highly regarded as an optimal cereal for granulation purposes because of its low fat content and the relatively low temperatures needed for starch gelatinization.
The raw material parameters evaluated for granulation are shown in Table 4, where the values of wheat can be compared to those of other cereals.

Table 4. Raw materials and their value according to their potential use for granulation.
In the second part of this section, we will delve into extrusion and its effects on the ingredients used for ruminant diets.


The application of thermal treatments on raw materials used in ruminant feed, can:

Maximize the digestibility of starch within the ration, while maintaining the fiber effect, reducing the fraction of non-degradable starch, and increasing the efficiency of amylolytic microflora in the rumen.
Improve the synthesis of milk protein, by increasing the amount of digestible protein within the intestine.
Improve the microbiological quality of products.
It is crucial to assess the carbon footprint and sustainability implications associated with various thermal treatments. Additionally, evaluating the returns on investment for these processing methods is essential.
The present and future landscape of beef cattle and dairy production requires the utilization of well-granulated feed to attain success. This holds particularly true for robotic milking systems. Hence, it is imperative to ensure the preservation of pellet quality, including its organoleptic attributes such as aroma, flavor, and texture.

Thermal treatment of raw materials used in ruminant diets- Part 1
DOWNLOAD ON PDF
Mastitis is considered to be one of the most costly diseases in dairy cattle, causing significant losses for the industry (Romero et al., 2018).

These losses are not only related to factors of economic interest like: quality and quantity of milk produced, antibiotic use or the need for additional labour. As they also include the impacts that this disease has on: animal welfare, cow lifespan, and public health.

Bacterial genera which include Staphylococcus spp. and Streptococcus spp. are considered to be common etiological agents behind udder inflammation. However, some viruses, fungi and algae can also cause mastitis (Ruegg et al., 2017).

Non-infectious factors like:
Genetics
Environmental conditions
Diets
Dietary supplements can also have an impact on the occurrence of mastitis and its severity (Abebe et al., 2016).
It has been well established that nutritional deficiencies lead to a weakened immune response, which is a predisposing factor for microbial invasion of the udder.

Minerals can be divided into two groups according to the concentration in which they are found in the body:
Macrominerals are present in plasma in relatively high concentrations (mg/ dl). These are obtained through the ration, and their dietary concentration is usually quantified in grams. These include:
Calcium (Ca)
Phosphorus (P)
Sodium (Na)
Chlorine (Cl)

Potassium (K)
Sulfur (S)
Magnesium (Mg)
Trace minerals on the other hand are found in relatively small amounts within plasma (mg/dl). Their inclusion in diets is usually quantified in ppm (parts per million). Some of the main elements in this group are:
Iron(Fe)
Copper(Cu)
Manganese(Mn)
Zinc(Zn)
Cobalt(Co)
Chromium(Cr)
Minerals have been reported as a group of nutrients that can influence udder health. Considering the fact that they participate in the formation of structural components of the organism, as well as allowing the proper functioning of enzymes, hormones, vitamins and cells.

Iodine (I)
Molybdenum (Mb)
Selenium (Se)

Mineral deficiencies in ruminants are mainly associated with specific metabolic disorders such as:
Peripartum hypocalcemia (milk fever)
Hypophosphatemia
Hypomagnesemia (tetany)
However,mineral deficiencies tend to not manifest themselves clinically. These are more likely to cause subclinical alterations such as immunosuppression. Presenting a predisposing factor for the appearance of infectious diseases, amongst which mastitis is a common culprit.

The dietary supply of a specific mineral represents the key factor that determines its concentration within the animal’s body. Thus, the dietary requirements of certain minerals according to the physiological state of the dairy cow, must always be takeninto account. Some of these are presented in Table 1.
Table 1. The recommended daily mineral intake for dairy cows, taking into account their physiological status (calves/ non-lactating), is determined based on the Nutritional Requirements of Dairy Cattle guidelines.
Mineral Requirements for non lactating cows Requirements for lactating cowss
Calcium 0,0154 gr/kg LW 0,106 g/kg LW
Phosphorus 1 gr/kg DM 2,5 gr/kg DM
Magnesium 3 mg/kg LW 10 mg/kg LW Copper 15,2 mg/kg DM 15,7 mg/kg DM
Selenium 0,3 mg/kg DM 0,3 mg/kg DM
Zinc 31 mg/kg DM 63 mg/kg DM
Source: National Research Council, 2001.
Assumed values for a Holstein dairy cow of 650 kg live weight (LW), producing 40 kg of milk per day.
Mineral supplementation is a well established practice in dairy production. Mainly aimed towards the improvement of cows’ reproductive performance (ChesterJones et al., 2013; Molefe and Mwanza, 2020). Nonetheless, its effects on cow health have also been investigated. Including the capacity to modulate the animal’s immune response which helps prevent the onset of mastitis.
This article aims to examine key aspects related to minerals that play a crucial role in dairy cattle. It delves into the consequences of mineral deficiencies and their impact on immune function and the development of mastitis.

Calcium (Ca) is involved in various functions of the body. It forms the structural components of the body and is essential for muscle contraction in both skeletal and smooth muscles.
This includes an adequate contraction of the nipple sphincter after milking, which is crucial to prevent microbial invasion of the udder (DeGaris et al., 2018).
Kimura et al. (2006) reported that Ca concentrations in mononuclear cells found in the peripheral blood of Jersey cows decreased before calving. This phenomenon has a direct effect on the normal functioning of leukocytes (Zhang et al., 2019).
Ducusin et al. (2003) and Martínez et al. (2012) reported a reduction in the phagocytic activity of neutrophils derived from hypocalcemic Holstein cows, when compared to normocalcemic cows.
These authors pointed to subclinical hypocalcemia as a predisposing factor for infections.
In a study conducted on Holstein cows, blood calcium concentrations were significantly lower in cows with hyperacute coliform mastitis compared to healthy cows (Hisaeda et al., 2020).
These authors suggest that this phenomenon is associated with the production of inflammatory cytokines in cows with mastitis, which decreases the secretion of Parathormone and the conversion of 25-OH vitamin D to 1,25D. Which consequently reduces blood calcium levels.

Phosphorus (P) is found in 85% of the skeletal system, as well as being an essential component in nucleic acids (DNA and RNA). It is also a part of highenergy compounds such as ATP. This mineral also acts as a pH buffer(buffer system) in body fluids.

Phosphorus deficiency during the time of birth and early calving, has been associated with:
Lower productivity.
Reduced feed intake.
Increased risk of morbidity in cows which have recently given birth.
Eisenberg et al. (2019) reported that hypophosphatemia negatively affects both phagocytic activity and granulocyte count in Holstein cows in transition. They reported such findings while investigating immune function and resistance to infectious diseases in dairy cattle.
However, the mechanism associated with impaired immune cell activity in phosphorus-deficient cows has not been fully elucidated.
Magnesium (Mg) plays an essential role in cellular metabolism and acts as a cofactor for more than 300 enzymes, including alkaline phosphatase and enzymes involved in the Krebs cycle.
The main site for the absorption of Mg++ is the rumen, which can be influenced by the type of diet and the presence of other minerals (Mattioli et al., 2006).
In regards to the immune system, Mg represents an integral part of the innate immune response.

Reports from other animal species, like rats, suggest that the ATP content in leukocytes tends to be lower in hypophosphatemic individuals. This can explain the reduction in their phagocytic activity (Kiersztejn et al., 1991).
Concerns regarding environmental contamination associated with faecal P levels, has led to recommendations for limiting manure P content. Resulting in a more restrictive use of this mineral in bovine nutrition.

Weglicki et al. (1992) observed elevated levels of proinflammatory cytokines (IL-6, TNF-α) in rats under Mg deprivation for three weeks. Van Orden et al. (2006) recorded an increase in total white blood cell counts in rats fed a diet with extremely low Mg compared to the control group (30 ppm).
proinflammatory citokines


Base on these results, magnesium can be considered as an important factor for a competent immune system. However, it’s still not clear whether Mg deficiency can act as a pro-inflammatory factor by itself or if it leads to immunosuppression, which then promotes inflammation.
Therefore, more studies assessing Mg deficiencies in livestock are required to fully understand its role.


It has been well documented that selenium supplementation can improve growth, reproductive performance and health status in cattle (Ullah et al., 2020).
Selenium deficiencies in cattle can cause:

Delayed growth in calves
Immunosuppression
Reproductive disorders
As far as the immune system is concerned, Se is contained in the active center of the enzyme glutathione peroxidase (GSH-Px), which confers it an antioxidant effect.
For such reasons, selenium supplementation can result in positive clinical responses to various conditions with increased oxidative damage. As is the case of mastitis.
In vitro studies (Machado et al., 2014) based on bovine neutrophils also evidenced that Se supplementation enhanced:
chemotactic migration
phagocytosis
superoxide dismutase (SOD) activity

intracellular antibacterial activity against S. aureus (Hoggan y col., 1990)
Recent studies (Jing et al., 2020) suggest that selenium may play a crucial role in immune and inflammatory regulation. Achieving this by influencing the differential expression of exosomal mRNAs in genes that are considered to be key for the prevention of bovine mastitis.
efficacy combined with a selenium preparation. They reported either a lower incidence of clinical mastitis, or a shorter duration of clinical signs when Holstein cows were supplemented with this mineral.
In turn, somatic cell counts have been negatively correlated with serum selenium levels (Wang et al., 2021).
Particular attention should be given to the chemical forms of selenium being used. Taking into account that organic sources (Se yeast and Se-Met) are considered to be more efficient bioavailable sources in comparison to inorganic Se.


Currently, the potential use of nano-Se in dairy cattle has gained great attention due to its multiple health benefits when compared to inorganic and organic Se sources (Pieszka et al., 2019).

Copper (Cu) is considered to be necessary for the structural and catalytic properties of cuproenzymes such as cytochrome-C oxidase, superoxide dismutase, etc.


In addition, it has also been attributed antimicrobial properties against bacteria that have been isolated from cows with mastitis.
According to Reyes-Jara et al. (2016), a concentration as low as 250 ppm of (Cu) can inhibit the growth of common mastitis causing microorganisms like: Escherichia coli and coagulase-negative Staphylococcus.
In vivo studies reported that dietary Cu supplementation during 100 days (Cu concentration in the experimental group of 20 ppm vs. 6.5 ppm in the control) resulted in a reduced clinical response of experimentally infected Holstein cows. These cows were subjected to an intramammary inoculation of E. coli (Scaletti et al., 2003).

Copper deficiencies result in impaired phagocytosis and decreased Cu, Zn-SOD activity (Babu and Failla, 1993).

Zinc (Zn) is a trace element that plays a crucial role in maintaining rumen microbiota and protein synthesis. It is also a cofactor for a number of oxidoreductases and participates in keratin formation.
Specific studies reported that dietary supplementation of Zinc contributed to reduce somatic cell counts (Chandra et al., 2015) and amyloid A levels in milk (Cope et al., 2009).

An intact mammary epithelium, that is impenetrable to microorganisms, is considered to be an innate part of the udder’s immune system.
Weng et al. (2018) reported an improvement in mammary epithelial integrity when Holstein cows were supplemented with Zn preparations.
Zinc is crucial for the adequate development and function of the cells that mediate innate immunity. As is the case for neutrophils.
When managing animal nutrition in a dairy farm, special attention must be given to minerals. Considering that they are involved in various biological processes with great importance for cows. Therefore, these elements influence key features in milk production.
Minerals are also essential for the proper functioning of immune cells. Hence, any mineral deficiency can lead to immunosuppression and the negative health effects that are associated to this phenomenon.
Mastitis is a common problem even on well-managed farms. In this context, mineral supplementation represents a tool through which the innate immunity of the mammary gland can be enhanced. Contributing to reduce the risks associated with udder inflammation.
DOWNLOAD ON PDF
 Mineral nutrition and its association with mastitis in dairy herds
Mineral nutrition and its association with mastitis in dairy herds





